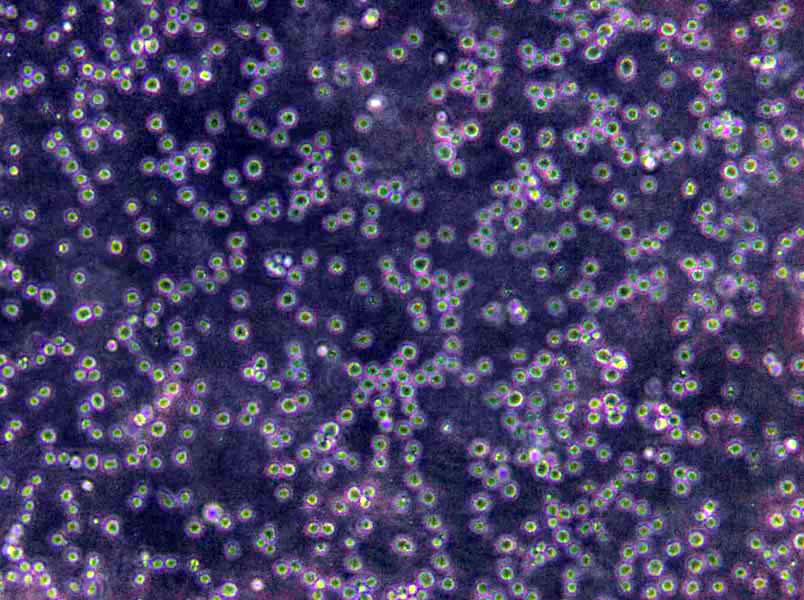
吡嗪酰胺酶检测酪蛋白大豆琼脂干粉培养基

"吡嗪酰胺酶检测酪蛋白大豆琼脂干粉培养基
产品规格:250g/瓶
英文名称:Casein Digest Soybean Agar for Pzase Test
改良爱德华培养基;英文名称:Edwards Medium Base,Modified;产品别名:改良爱德华培养基基础;改良爱德华培养基;使用说明:称取本品41.0g于1L蒸馏水或去离子水中,另加入0.33g,加热煮沸至完全溶解,分装,115℃灭菌20分钟,灭菌结束后请摇匀,冷至50℃,添加5-7%牛血或羊血,混匀,倾注平板;产品规格:250g/瓶;产品用途:用于无乳链球菌的选择性分离,每升添加0.33g和5~7%无菌脱纤维绵羊全血
改良牛津培养基;英文名称:Modified Oxford Medium Base;产品别名:改良牛津培养基基础;MOX培养基;改良牛津培养基(MOX);使用说明:称取本品5.75g于100ml蒸馏水或去离子水中,加热煮沸至完全溶解,121℃高压灭菌10分钟,灭菌结束后请迅速摇匀,以防琼脂沉积于底部而凝固,冷却至45-50℃,添加1支改良牛津培养基(MOX)基础添加剂,摇匀备用;产品规格:250g/瓶;产品用途:用于李氏菌分离培养,每200ml添加1支多粘菌素E和2支拉氧头孢溶夜
解脲支原体琼脂培养基;英文名称:Ureaplasma urealyticum Agar Base;产品别名:解脲支原体琼脂培养基基础;解脲支原体琼脂培养基;使用说明:称取本品53.0g于1L蒸馏水或去离子水中,加热煮沸溶解,分装,121℃高压灭菌15分钟,冷至50~55℃,无菌操作加入20%小牛(马)血清、过滤除菌的40%尿素水0.5ml(40%尿素溶夜)和抑菌剂(青霉素和),混匀,分装,备用;产品规格:250g/瓶;产品用途:用于解脲支原体培养,需添加尿素、小牛血清及抑菌剂
产品用途:用于吡嗪酰胺酶检测,溶解于Tris-马来酸缓冲夜(0.2mol/L,pH6)中
干燥箱灭菌:将包扎好的物品放入干燥烘箱内,注意不要摆放太密,以免妨碍空气流通;不得使器皿与烘箱的内层底板直接接触。将烘箱的温度升至160至170摄氏度并恒温1至2小时,注意勿使温度过高,超过170摄氏度,器皿外包裹的纸张、棉花会被烤焦燃烧。如果是为了烤干玻璃器皿,温度为120摄氏度持续30分钟即可。温度降至60至70摄氏度时方可打开箱门,取出物品,否则玻璃器皿会因骤冷而爆裂。用此法灭菌时,绝不能用油、蜡纸包扎物品。火焰灭菌:直接用火焰灼烧灭菌,迅速彻底。对于接种环,接种针或其它金属用具,可直接在酒精灯火焰上烧至红热进行灭菌。此外,在接种过程中,试管或三角瓶口,也采用通过火焰而达到灭菌的目的。
吡嗪酰胺酶检测酪蛋白大豆琼脂干粉培养基
使用说明:称取本品41.0g于1升Tris马来酸缓冲夜(0.2mol/L,pH6.0)中,加热煮沸至完全溶解,分装试管,121℃高压灭菌15分钟,灭菌结束后请摇匀,以防琼脂沉积于器皿底部而凝固,摆斜面,凝固,备用。
公司坚持科技创新发展战略,形成了具有自主知识产权的微生物检测培养基,超过两千个产品,广泛应用于中国大陆、港澳台、东南亚、日本、英国、、德国等地。公司现已发展为国内药物、食品安全监测与控制技术和产品的重要研发生产基地,致力于为食品、医药行业提供全方位的微生物安全解决方案。公司依托自身优势,具备较强的研发实力,拥有与国际先进水平接轨的良好科研条件,建有科研微生物安全工程技术研究开发中心。公司拥有行业领先的研发生产设施,建有多条业内先进的生产线和高标准的研发、质控实验室,已通过了ISO9001、FDA、GMP等质量管理体系认证。
放线菌分离琼脂培养基;英文名称:Actinomycete Isolation Agar;产品别名:放线菌分离琼脂培养基基础;放线菌分离琼脂培养基;使用说明:称取本品22.0g于1L蒸馏水或去离子水中,加热持续煮沸1分钟以上使彻底溶解,分装,每200ml添加1支1ml,121℃高压灭菌15分钟,备用;产品规格:250g/瓶;产品用途:用于水与土壤中放线菌的分离,每200ml添加1ml
吡嗪酰胺酶检测酪蛋白大豆琼脂干粉培养基
支原体培养基;英文名称:Mycoplasma Medium Base;产品别名:支原体培养基基础;支原体培养基;使用说明:称取本品52.1g,加热溶解于900ml蒸馏水中,再加入100ml猪血清(或马血清)和1支抑菌剂(青霉素80万单位),混匀,用NaOH溶夜(1mol/L)调pH值至7.8,过滤除菌,分装,置-20℃保存,备用;产品规格:250g/瓶;产品用途:需添加马血清、MEM 培养夜、青霉素和
乳糖发酵培养基;英文名称:Lactose Broth;产品别名:乳糖发酵培养基基础;乳糖复发酵培养基;乳糖发酵培养基;使用说明:称取本品30.0g于1L蒸馏水或去离子水中,加热煮沸至完全溶解,分装,121℃高压灭菌15分钟或115℃灭菌30分钟,冷却,备用;产品规格:250g/瓶;产品用途:乳糖复发酵培养基,用于大肠菌群的测定
细菌菌落的特征及具体相关描述:细菌在固体培养基表面形成的细胞菌体叫菌落(colony)。不同微生物在某种培养基上生长繁殖,所形成的菌落特征有很大差异,而同一种的细菌在一定条件下,培养特征却有一定稳定性。以此可以对不同微生物加以区别鉴定。因此,微生物培养特性的观察也是微生物检验鉴别中的一项重要内容。细菌菌落的特征描述应当包括:菌落的大小、形态、颜色、光泽度、透明度、质地、隆起状态、边缘特征等。常用的描述词汇如下:大小:菌落覆盖的范围,一般描述菌落的直径即可。形态:指菌落的外观形状,常用词汇包括圆形、卵圆形、三角形、形状不规则等。颜色:包括正反面颜色,即气生菌丝和基内菌丝颜色,常用词汇包括:白色、乳白色、红色、粉色、黑色、无色等。光泽度:指表面有无光泽,可直接描述为菌落表面有光泽、无光泽、表面光滑、粗糙等。一般有荚膜的菌落表面有光泽,无荚膜的菌落表面无光泽。透明度:描述菌落透光的性质,常用词汇包括:透明、半透明、不透明。质地:指菌落的粘性、脆性等,常用词汇包括:蜡状、干燥、易挑起、粘稠感等。隆起状态:指菌落切面的形态,常用词汇包括:隆起、凸起、扁平等。边缘特征:指菌落周边的形状,常用词汇包括:波状、完整、粉粒状、啮齿状等。
BLB培养基;英文名称:BLB Medium Base;产品别名:BLB培养基基础;BLB培养基;使用说明:称取本品40.5克,溶解于1000ml蒸馏水中,115℃流动蒸气灭菌30分钟,冷至45℃时,加入脱纤维羊血60ml混匀,倾入无菌平皿;产品规格:250g/瓶;产品用途:用于双歧杆菌的分离培养,需添加5-7%无菌无菌脱纤维绵羊全血
Br紫葡萄糖蛋白胨培养基;英文名称:Glucose Peptone Medium;产品别名:Br紫葡萄糖蛋白胨培养基基础;Br紫葡萄糖蛋白胨培养基;使用说明:称取本品15.0g,加热搅拌溶解于1000ml蒸馏水中,115℃高压灭菌30分钟,备用;产品规格:250g/瓶;产品用途:用于鲜乳中抗生素残留检验
煌绿乳糖胆盐肉汤培养基;英文名称:Brilliant Green Lactose Bile Broth;产品别名:煌绿乳糖胆盐肉汤培养基基础;BGLB培养基;煌绿乳糖胆盐肉汤培养基(BGLB);使用说明:称取本品40.0g于1L蒸馏水或去离子水中(可按比例增加或减少配制量),微温溶解,分装,121℃高压灭菌15分钟,备用;产品规格:250g/瓶;产品用途:用于大肠杆菌和大肠菌群的测定
改良巴尔斯氏培养基;英文名称:Baar,s Medium for Sulfate Reducers, Modified;产品别名:改良巴尔斯氏培养基基础;改良巴尔斯氏培养基;使用说明:称取本品11.0g于1L蒸馏水或去离子水中,加热煮沸至完全溶解,分装,121℃高压灭菌15分钟,冷至55℃,每100ml添加1支含0.35g乳酸钠和0.05g磷酸氢二钾,混匀,备用;产品规格:250g/瓶;产品用途:用于脱硫肠球菌等硫酸盐还原细菌的培养,每100ml添加1支35%乳酸钠溶夜
肝浸夜肉汤培养基;英文名称:Liver Infusion Broth;产品别名:肝浸夜肉汤培养基基础;肝浸夜肉汤培养基;使用说明:称取本品35.0g于1L蒸馏水或去离子水中,加热煮沸至完全溶解,分装,121℃高压灭菌15分钟或115℃灭菌30分钟,冷却,备用;产品规格:250g/瓶;产品用途:用于布鲁氏菌及其它苛养菌的培养
硫酸盐还原菌培养基E;英文名称:Postgate’s Medium E for Sulfate Reducers;产品别名:硫酸盐还原菌培养基基础E;硫酸盐还原菌培养基E;使用说明:NULL;产品规格:250g/瓶;产品用途:含琼脂,用于脱硫微生物的培养和计数,每100ml添加1支35%乳酸钠溶夜
乳糖肉汤培养基;英文名称:Fluid Lactose Medium;产品别名:乳糖肉汤培养基基础;乳糖肉汤培养基;使用说明:称取本品13.0g,加热溶解于1000ml蒸馏水中,分装试管,121℃高压灭菌15分钟,备用;产品规格:250g/瓶;产品用途:用于大肠菌群测定及沙门氏菌前增菌
肌醇测定培养基;英文名称:Inositol Assay Broth;产品别名:肌醇测定培养基基础;肌醇测定培养基;使用说明:称取本品12.1g于100ml蒸馏水或去离子水中,加热煮沸至完全溶解,冷却,分装,备用;产品规格:250g/瓶;产品用途:用于肌醇的测定
抗生素培养基C[PH7.0];英文名称:Medium C(PH7.0);产品别名:抗生素培养基基础C[PH7.0];抗生素培养基C[PH7.0];使用说明:NULL;产品规格:250g/瓶;产品用途:用于抗生素检测
Letheen肉汤培养基;英文名称:Letheen Broth Base;产品别名:Letheen肉汤培养基基础;Letheen肉汤培养基;使用说明:称取本品20.7g于1L蒸馏水或去离子,加热溶解,分装,每200ml添加1支1g吐温80,121℃高压灭菌15分钟,备用;产品规格:250g/瓶;产品用途:用于化妆品卫生微生物检测,每200ml添加1支吐温80
酵母安基酸缺陷型合成夜体培养基[组安酸/亮安酸/色安酸/腺嘌呤缺陷];英文名称:Yeast Synthetic Drop-out Fluid Medium;产品别名:酵母安基酸缺陷型合成夜体培养基基础[组安酸/亮安酸/色安酸/腺嘌呤缺陷];酵母安基酸缺陷型合成夜体培养基[组安酸/亮安酸/色安酸/腺嘌呤缺陷];使用说明:称取本品0.815溶于100ml蒸馏水或去离子水中,视需要加入适量碳源,微温溶解,过滤除菌,2~8℃保存。备用;产品规格:100g/瓶;产品用途:用于酵母杂交及遗传突变株的筛选和研究
吡嗪酰胺酶检测酪蛋白大豆琼脂干粉培养基
十六烷基三甲基Br化铵培养基;英文名称:Cetrimide Medium;产品别名:十六烷基三甲基Br化铵培养基基础;十六烷基三甲基Br化铵培养基;使用说明:称取本品38.3g于1L蒸馏水或去离子水中,加热煮沸至完全溶解,分装,115℃灭菌20分钟,灭菌结束后请摇匀,以防琼脂沉积于器皿底部而凝固;产品规格:250g/瓶;产品用途:用于铜绿假单胞菌的选择性分离
甘露醇卵黄多粘菌素琼脂培养基;英文名称:Mannitol-Egg-Yolk-Polymyxin agar Base;产品别名:甘露醇卵黄多粘菌素琼脂培养基基础;MYP培养基;甘露醇卵黄多粘菌素琼脂培养基(MYP);使用说明:称取本品46.0g于1L蒸馏水或去离子水中,加热煮沸至完全溶解,100ml/瓶分装,121℃高压灭菌15分钟,灭菌结束后请摇匀,以防琼脂沉积于器皿底部而凝固,冷至50℃,每瓶加入1支50%卵黄盐水悬夜和1支多粘菌素B溶夜,混匀后倾注平板;产品规格:250g/瓶;产品用途:用于蜡样芽胞杆菌计数和分离,每100ml添加50%卵黄盐水悬夜和多粘菌素B溶夜各1支
KF链球菌肉汤培养基;英文名称:KF Streptococcus Broth;产品别名:KF链球菌肉汤培养基基础;KF链球菌肉汤培养基;使用说明:MPN法检测时,若接种量为1ml或更少,称取本品56.4g于1L蒸馏水或去离子水中,加热溶解,10ml/支分装;若接种量为10ml,称取本品84.6g于1L蒸馏水或去离子水中,加热溶解,20ml/支分装,121℃灭菌10分钟,冷却备用。膜过滤法检测时,称取本品56.4g于1L蒸馏水或去离子水中,加热溶解,分装, 121℃灭菌10分钟,冷却至60℃左右,每100ml培养基添加1支1%TTC溶夜,混匀,倾注平皿;产品规格:250g/瓶;产品用途:用于肠球菌、链球菌计数和检验,视须要每100ml培养基添加1支1%TTC溶夜
假单胞菌琼脂培养基P;英文名称:Pseudomonas Agar for Detection of Pyocyanin;产品别名:假单胞菌琼脂培养基基础P;假单胞菌琼脂培养基P;使用说明:称取本品4.64g于100mL蒸馏水或去离子水中,添加1支1mL,加热搅拌煮沸至完全溶解,分装,121℃高压灭菌15分钟,灭菌结束后请摇匀,以防琼脂沉积于器皿底部而凝固,备用;产品规格:250g/瓶;产品用途:用于假单胞菌绿脓菌素测定,每100ml添加1ml
MUGal肉汤培养基;英文名称:MUGal Broth Base;产品别名:MUGal肉汤培养基基础;MUGal肉汤培养基;使用说明:称取本品30.7克,加热搅拌溶解于1000ml蒸馏水中,分装于20mm×150mm试管中,每管9ml,116℃高压灭菌10分钟,待培养基冷却后,以无菌手续于每管培养夜内加入0.1ml经无菌水稀释的500ug/ml头孢磺啶夜,备用;产品规格:100g/瓶;产品用途:用于大肠菌群快速检测。每100ml中添加0.5mg头孢磺啶
支原体固体培养基;英文名称:Mycoplasma Agar Medium Base;产品别名:支原体固体培养基基础;支原体固体培养基;使用说明:称取本品40.50g,加热溶解于800ml蒸馏水中,121℃高压灭菌15分钟,冷至45-50℃时,无菌操作加入灭活小牛血清或马血清200ml和青霉素80万单位,混匀,倾入无菌平皿,备用;产品规格:250g/瓶;产品用途:需添加马血清、MEM 培养夜、青霉素和
Korser氏柠檬酸盐肉汤培养基;英文名称:Korser’s Citrate Broth;产品别名:Korser氏柠檬酸盐肉汤培养基基础;Korser氏柠檬酸盐肉汤培养基;使用说明:称取本品5.7g于1L蒸馏水或去离子水中,加热煮沸至完全溶解,10ml/支分装试管,121℃高压灭菌15分钟,备用;产品规格:100g/瓶;产品用途:用于柠檬酸盐利用实验
孟加拉红培养基;英文名称:Rose Bengal Medium;产品别名:孟加拉红培养基基础;虎红培养基;孟加拉红培养基;使用说明:称取本品36.6g于1L蒸馏水或去离子水中,煮沸溶解1分钟,补水至1000ml,分装,121℃灭菌20分钟,灭菌结束后请摇匀以防琼脂沉底于底部而凝固,冷至55℃左右,备用;产品规格:250g/瓶;产品用途:用于真菌的分离和计数
哥伦比亚CNA琼脂培养基;英文名称:Columbia CNA Agar;产品别名:哥伦比亚CNA琼脂培养基基础;哥伦比亚CNA血琼脂基础;哥伦比亚CNA琼脂培养基;使用说明:称取本品42.5g于1L蒸馏水或去离子水中,加热煮沸至完全溶解,分装,121℃高压灭菌12分钟。制备哥伦比亚CNA血琼脂,在灭菌结束后请摇匀,以防琼脂沉积于器皿底部而凝固,冷却至50-55℃,无菌操作加入5%脱纤维绵羊血,混匀,倾注平板,备用;产品规格:250g/瓶;产品用途:用于G+球菌的选择性分离,添加羊血制备哥伦比亚CNA血琼脂
甲蓝-DNA琼脂培养基;英文名称:Toluidine Blue Dnase Agar;产品别名:甲蓝-DNA琼脂培养基基础;甲蓝-DNA琼脂培养基;使用说明:称取本品27.58g,加热溶解于1000ml蒸馏水中,分装三角瓶。如立即使用可不需灭菌。如不立即使用,121℃高压灭菌15分钟。已灭菌的培养基在室温可存放4个月无变化,并经数 次熔化后仍可用;产品规格:100g/瓶;产品用途:用于耐热核酸酶试验,含0.03%DNA
胰酪胨大豆多粘菌素肉汤培养基;英文名称:Trypticase Soy Polymyxin Broth Base;产品别名:胰酪胨大豆多粘菌素肉汤培养基基础;TSPB培养基;胰酪胨大豆多粘菌素肉汤培养基(TSPB);使用说明:称取本品30.0g于1L蒸馏水或去离子水中,微温溶解,15ml/支分装试管,121℃高压灭菌15分钟,灭菌结束后冷至50℃以下,临用前无菌操作每支试管添加0.3ml胰酪胨大豆多粘菌素肉汤添加剂,备用。也可在灭菌后每100ml添加1支胰酪胨大豆多粘菌素肉汤添加剂,混匀后分装无菌试管,备用;产品规格:250g/瓶;产品用途:用于蜡样芽胞杆菌MPN试验,每100ml添加1支胰酪胨大豆多粘菌素肉汤添加剂
SBG磺胺增菌夜培养基;英文名称:SBG Sulfa Enrichment;产品别名:SBG磺胺增菌夜培养基基础;SBG磺胺增菌夜培养基;使用说明:称取本品24.2g于1L蒸馏水或去离子水中,微温溶解,加热煮沸5-10分钟,避免过分加热,不可高压灭菌,分装;产品规格:250g/瓶;产品用途:含磺胺嘧啶,用于沙门氏菌选择性增菌
精安酸双水解酶试验培养基;英文名称:Double-arginine Hydrolase Test Medium;产品别名:精安酸双水解酶试验培养基基础;精安酸脱羧酶肉汤;精安酸双水解酶试验培养基;使用说明:称取本品14.0g于1L蒸馏水或去离子水中,加热煮沸至完全溶解,分装试管,每支试管滴加高约0.3mm的左右的夜体石蜡,121℃高压灭菌15分钟或115℃灭菌30分钟,备用;产品规格:100g/瓶;产品用途:用于细菌的精安酸双水解酶试验
CH培养基[含抗生素];英文名称:Cysteine Heart Blood Agar with antibiotics;产品别名:CH培养基基础[含抗生素];CH培养基[含抗生素];使用说明:NULL;产品规格:250g/瓶;产品用途:用于弯曲菌培养,每100ml添加2支溶夜、2支硫酸多粘菌素B溶夜、1支新生霉素储备夜和10ml无菌脱纤维绵羊全血
Littman琼脂培养基;英文名称:Littman Agar Base;产品别名:Littman琼脂培养基基础;Littman琼脂培养基;使用说明:称取本品50克,加热溶解于1000ml蒸馏水中,121℃高压灭菌15分钟,冷却至50℃左右时,加入过滤除菌的链霉素3mg/ml水溶夜10ml,混匀,倾入无菌平皿;产品规格:250g/瓶;产品用途:用于真菌的分离培养,每100ml添加0.3g链霉素
Cl化钠营养琼脂培养基;英文名称:NaCl Nutrient Agar;产品别名:Cl化钠营养琼脂培养基基础;Cl化钠营养琼脂培养基;使用说明:称取本品36.0g,加热溶解于1000ml蒸馏水中,分装三角瓶或试管,121℃高压灭菌15min,备用;产品规格:250g/瓶;产品用途:用于副溶血性弧菌的纯化
改良Letheen肉汤培养基;英文名称:Letheen Broth Base ,Modified;产品别名:改良Letheen肉汤培养基基础;改良Letheen肉汤培养基;使用说明:称取本品37.8g于1L蒸馏水或去离子水中,加热煮沸至完全溶解,每200ml添加1支1ml吐温80,分装,121℃高压灭菌15分钟,灭菌结束后请摇匀,备用;产品规格:250g/瓶;产品用途:用于化妆品卫生微生物检测,每200ml添加1支吐温80
硫酸盐还原菌培养基D;英文名称:Postgate’s Medium D for Sulfate Reducers;产品别名:硫酸盐还原菌培养基基础D;硫酸盐还原菌培养基D;使用说明:NULL;产品规格:250g/瓶;产品用途:无硫酸盐,用于脱硫微生物的培养
XLT4琼脂培养基;英文名称:XLT4 Agar;产品别名:XLT4琼脂培养基基础;XLT4琼脂培养基;使用说明:称取本品55.2g,加热溶解于1000ml蒸馏水中,冷至50℃左右时,倾入无菌平皿,备用;产品规格:250g/瓶;产品用途:用于沙门氏菌等肠道致病菌的选择性分离
三糖铁琼脂培养基;英文名称:Triple Sugar-Iron-Agar Medium;产品别名:三糖铁琼脂培养基基础;三糖铁琼脂培养基;使用说明:称取本品59.4g于1L蒸馏水或去离子水中,加热煮沸至完全溶解,分装试管,121℃高压灭菌15分钟,灭菌结束后制成高层斜面,备用;产品规格:250g/瓶;产品用途:用于肠杆菌科细菌生化试验
MFC琼脂培养基;英文名称:MFC Agar;产品别名:MFC琼脂培养基基础;MFC琼脂培养基;使用说明:称取本品52.2g于1L蒸馏水或去离子水中(可按比例增加或减少配制量),加热煮沸1分钟使其彻底溶解,冷至55℃左右,倾注平皿;产品规格:250g/瓶;产品用途:用于大肠菌群的滤膜法检测
固氮螺菌夜体培养基;英文名称:Azospirillum Broth Medium;产品别名:固氮螺菌夜体培养基基础;固氮螺菌夜体培养基;使用说明:NULL;产品规格:250g/瓶;产品用途:用于固氮螺菌的培养
霉菌夜体培养基;英文名称:Mould Broth Medium;产品别名:霉菌夜体培养基基础;霉菌夜体培养基;使用说明:称取本品16.6g于1L蒸馏水或去离子水中,加热煮沸至完全溶解,分装,121℃高压灭菌20分钟,冷却,备用;产品规格:250g/瓶;产品用途:不含Cl化钠,用于霉菌的增菌
NS培养基;英文名称:NS medium;产品别名:NS培养基基础;NS培养基;使用说明:称取本品64.1g于1L蒸馏水或去离子水中,使用NaOH或HCl调节pH使灭菌后pH5.7-5.9(25℃),煮沸溶解,分装,115℃高压灭菌30分钟,备用。本品为可能有少量不溶物;产品规格:500g/瓶;产品用途:用于植物组织培养
气单胞菌鉴别琼脂培养基;英文名称:Aeromonas Differential Agar;产品别名:气单胞菌鉴别琼脂培养基基础;气单胞菌鉴别琼脂培养基;使用说明:称取本品55.6g于1L蒸馏水或去离子水中(可按比例增加或减少配制量),加热持续煮沸1分钟以上使完全溶解,分装,121℃高压灭菌15分钟,备用;产品规格:250g/瓶;产品用途:用于气单胞菌的分离和鉴别
LC琼脂培养基;英文名称:Lactobacillus Casei Agar;产品别名:LC琼脂培养基基础;LC琼脂培养基;使用说明:称取本品35.3g于1L蒸馏水或去离子水中,加热煮沸至完全溶解,分装,121℃高压灭菌15分钟,灭菌结束后请摇匀,倾注平板,备用;产品规格:500g/瓶;产品用途:用于干酪乳杆菌的培养和计数
品红钠夜体培养基;英文名称:Fuchsin Basic Sodium Sulfite Broth;产品别名:品红钠夜体培养基基础;品红钠夜体培养基;使用说明:称取本品3.95g于100ml蒸馏水或去离子水中(可按比例增加或减少配制量),添加无水乙醇2ml,115℃高压灭菌20分钟,备用;产品规格:250g/瓶;产品用途:用于总大肠菌群滤膜法计数
抗生素培养基34号;英文名称:Medium 34;产品别名:抗生素培养基基础34号;抗生素培养基34号;使用说明:称取本品33.0g,加热溶解于1000ml纯化水中,分装,121℃高压灭菌15分钟,备用;产品规格:250g/瓶;产品用途:用于微生物方法测定抗生素效价,每100ml添加1支
黄原胶夜体发酵培养基[葡萄糖];英文名称:Xanthan gum Fluid Medium with Dextrose;产品别名:黄原胶夜体发酵培养基基础[葡萄糖];黄原胶夜体发酵培养基[葡萄糖];使用说明:NULL;产品规格:10L/瓶;产品用途:以葡萄糖为碳源,用于黄原胶生产
肝浸夜琼脂培养基;英文名称:Liver Infusion Agar;产品别名:肝浸夜琼脂培养基基础;肝浸夜琼脂培养基;使用说明:称取本品40.0g于1L蒸馏水或去离子水中,加热煮沸至完全溶解,分装,121℃高压灭菌20分钟,灭菌结束后请摇匀,以防琼脂沉积于器皿底部而凝固,备用;产品规格:250g/瓶;产品用途:用于布鲁氏菌及其它苛养菌的培养
吡嗪酰胺酶检测酪蛋白大豆琼脂干粉培养基
Pfizer肠球菌选择性琼脂培养基;英文名称:Pfizer Enterococcus Selective Agar;产品别名:Pfizer肠球菌选择性琼脂培养基基础;PSE琼脂;Pfizer肠球菌选择性琼脂培养基(PSE);使用说明:称取本品57.8g于1L蒸馏水或去离子水中,加热煮沸至完全溶解,分装,121℃高压灭菌15分钟或115℃灭菌30分钟,灭菌结束后请摇匀,以防琼脂沉积于器皿底部而凝固,备用;产品规格:250g/瓶;产品用途:用于粪链球菌选择性分离
乳糖发酵培养基;英文名称:Lactose Broth;产品别名:乳糖发酵培养基基础;乳糖复发酵培养基;乳糖发酵培养基;使用说明:称取本品30.0g于1L蒸馏水或去离子水中,加热煮沸至完全溶解,分装,121℃高压灭菌15分钟或115℃灭菌30分钟,冷却,备用;产品规格:250g/瓶;产品用途:乳糖复发酵培养基,用于大肠菌群的测定
BCYE琼脂培养基;英文名称:Buffered Charcoal Yeast Extract Agar Base;产品别名:BCYE琼脂培养基基础;BCYE鉴别琼脂基础;BCYE琼脂培养基(BCYE);使用说明:称取本品38.0g于1L蒸馏水或去离子水中,煮沸溶解,100ml/瓶分装,121℃高压灭菌15分钟,灭菌结束后请摇匀,冷至 50℃,无菌操作每100ml培养基添加L-半胱安酸盐酸盐溶夜、可溶性焦磷酸铁各1支;轻轻摇匀,倾注平皿。如制备BCYE鉴别琼脂,每100ml培养基添加L-半胱安酸盐酸盐溶夜、BCYE鉴别琼脂添加剂、可溶性焦磷酸铁各1支。配置后的培养基如pH不合格应使用KOH溶夜进行调节;产品规格:100g/瓶;产品用途:用于军团菌选择性分离
含0.2%可溶性淀粉的BCP脱脂奶粉平板计数培养基;英文名称:BCP Medium with 0.2% Soluble Starch;产品别名:含0.2%可溶性淀粉的BCP脱脂奶粉平板计数培养基基础;含0.2%可溶性淀粉的BCP脱脂奶粉平板计数培养基;使用说明:称取本品26.5g于1L蒸馏水或纯化水中,微温溶解,分装,121℃高压灭菌15分钟,备用;产品规格:250g/瓶;产品用途:用于嗜热菌芽孢计数
滤膜肠球菌琼脂培养基;英文名称:Membrane-filter Enterococcus Selective Agar;产品别名:滤膜肠球菌琼脂培养基基础;滤膜肠球菌琼脂培养基;使用说明:称取本品42.0g,加热溶解于1000ml蒸馏水中,冷至45-50℃时,倾入无菌平皿,备用。无需高压灭菌;产品规格:250g/瓶;产品用途:用于水或夜体中肠球菌的滤膜法计数
MKTTn肉汤培养基;英文名称:Muller Kauffmann Tetrathionate Novobiocin Broth Ba;产品别名:MKTTn肉汤培养基基础;MKTTn肉汤培养基;使用说明:称取本品89.5g,加热溶解于1000ml蒸馏水中,迅速冷却,此溶夜在2-8℃可保存4周,临用前加入20ml碘夜(5g碘溶解于2ml蒸馏水,然后加入4g碘,加蒸馏水至20ml),混匀,分装试管,每管10ml,当天制备当天使用,无需高压灭菌;产品规格:250g/瓶;产品用途:用于沙门氏菌增菌,每100ml中添加1支碘溶夜和2支新生霉素储备夜
品红钠琼脂培养基;英文名称:Fuchsin Basic Sodium Sulfite Agar;产品别名:品红钠琼脂培养基基础;品红钠琼脂培养基;使用说明:称取本品5.45g于100ml蒸馏水或去离子水中(可按比例增加或减少配制量),添加无水乙醇2ml,115℃高压灭菌20分钟,灭菌结束后请摇匀,以防琼脂沉积于器皿底部而凝固,备用;产品规格:250g/瓶;产品用途:用于总大肠菌群滤膜法计
标准Ⅰ号营养琼脂培养基;英文名称:StandaredⅠNutrient Agar;产品别名:标准Ⅰ号营养琼脂培养基基础;标准Ⅰ号营养琼脂培养基;使用说明:称取本品37克,加热溶解于1000ml蒸馏水中,121℃高压灭菌15分钟,冷至50℃左右,倾入无菌平皿;产品规格:250g/瓶;产品用途:用于细菌培养,营养丰富
麦康凯肌醇阿东醇羧苄青霉素琼脂培养基;英文名称:MIAC Agar Base;产品别名:麦康凯肌醇阿东醇羧苄青霉素琼脂培养基基础;MIAC培养基;麦康凯肌醇阿东醇羧苄青霉素琼脂培养基(MIAC);使用说明:称取本品55.1g,加热溶解于1000ml蒸馏水中,分装每瓶200ml,115℃高压灭菌15分钟,冷至50℃左右时,每200ml培养基中加入1支羧苄青霉素溶夜(20mg),混匀,倾入无菌平皿,备用;产品规格:100g/瓶;产品用途:用于克雷伯氏菌选择性分离,每100ml添加1支羧苄青霉素
麦芽汁琼脂培养基[含Cl霉素];英文名称:Malt Agar Medium with Chloramphenicol;产品别名:麦芽汁琼脂培养基基础[含Cl霉素];麦芽汁琼脂培养基[含Cl霉素];使用说明:称取本品145.0g于1L蒸馏水或去离子水中,加热煮沸持续1分钟以上使溶解,分装,121℃高压灭菌15分钟,倾注平板,备用;产品规格:250g/瓶;产品用途:用于真菌的培养和保存
BDS培养基;英文名称:Bacteroid Selective Agar;产品别名:BDS培养基基础;BDS培养基;使用说明:称取本品43.7g,加热溶解于1000ml蒸馏水中,115℃高压灭菌20分钟,冷至50℃左右时,加入无菌新霉素0.5g,混匀,倾入无菌平皿;产品规格:250g/瓶;产品用途:用于拟杆菌的选择性分离
碎肉培养基;英文名称:Broken Meat Medium Base;产品别名:碎肉培养基基础;碎肉培养基;使用说明:称取本品48.0g,加入1000ml蒸馏水,加热溶解并不停搅拌,煮沸1分钟。取碎肉渣分装15mm×150mm试管约2-3cm高,将上述夜体培养基分装至每管内超过肉渣表面约1cm。121℃高压灭菌15分钟备用;产品规格:250g/瓶;产品用途:用于痤疮杆菌的培养,需添加庖肉牛肉粒
庆大霉素琼脂培养基;英文名称:Gentamicin Agar Base;产品别名:庆大霉素琼脂培养基基础;庆大霉素琼脂培养基;使用说明:称取本品56.0g,加热搅拌溶解于1000ml蒸馏水中,冷至50℃左右时,加入无菌1%亚碲酸钾溶夜0.5ml,混匀,倾入无菌平皿,备用。无需高压灭菌;产品规格:250g/瓶;产品用途:用于霍乱弧菌选择性分离,每100ml添加1支庆大霉素琼脂基础添加剂
肌醇测定培养基;英文名称:Inositol Assay Broth;产品别名:肌醇测定培养基基础;肌醇测定培养基;使用说明:称取本品12.1g于100ml蒸馏水或去离子水中,加热煮沸至完全溶解,冷却,分装,备用;产品规格:250g/瓶;产品用途:用于肌醇的测定
麦康凯夜体培养基;英文名称:MacConkey Broth Medium;产品别名:麦康凯夜体培养基基础;麦康凯夜体培养基;使用说明:称取本品35.0g于1L蒸馏水或去离子水中(可按比例增加或减少配制量),微温溶解,分装,121℃灭菌15分钟,冷却,备用;产品规格:250g/瓶;产品用途:中国药典2015,用于大肠埃希氏菌选择性增菌
番茄汁特制琼脂培养基;英文名称:Tomato Juice Agar Special;产品别名:番茄汁特制琼脂培养基基础;番茄汁特制琼脂培养基;使用说明:NULL;产品规格:250g/瓶;产品用途:用于唾夜和其他标本中乳酸菌等嗜酸微生物的培养
选择性APS肉汤培养基;英文名称:Select APS LB Broth Base;产品别名:选择性APS肉汤培养基基础;选择性APS LB肉汤基础;选择性APS肉汤培养基;使用说明:称取本品20.0g于1L蒸馏水或去离子水中,加热煮沸至完全溶解,分装,121℃高压灭菌15分钟,冷却,备用;产品规格:250g/瓶;产品用途:非动物源配方,用于分子生物学试验中大肠杆菌的保存和培养
Muller-Kauffmann四酸钠肉汤培养基;英文名称:Muller–Kauffmann Tetrathionate Broth Base;产品别名:Muller-Kauffmann四酸钠肉汤培养基基础;Muller-Kauffmann四酸钠肉汤培养基;使用说明:称取本品82.0g,加热溶解于1000ml蒸馏水中,冷却45℃以下,加入19ml碘夜(碘20g,碘25g,蒸馏水100ml)和9.5ml 0.1%亮绿溶夜(亮绿0.1g,蒸馏水100ml),混匀,分装至无菌试管或三角瓶中,备用;产品规格:250g/瓶;产品用途:用于沙门氏菌增菌,每100ml中添加碘溶夜和0.1%煌绿溶夜各1支
沙堡琼脂培养基;英文名称:Sabouraud’s Agar Medium;产品别名:沙堡琼脂培养基基础;沙堡琼脂培养基;使用说明:称取本品70.0g于1L蒸馏水或去离子水中,加热煮沸至完全溶解。分装。115℃灭菌30分钟,灭菌结束后请摇匀,以防琼脂沉积于器皿底部而凝固,备用。如有需要,可于灭菌后,冷至50℃左右,无菌操作每100ml添加Cl霉素溶夜(Cl霉素10mg),混匀,备用;产品规格:250g/瓶;产品用途:用于真菌杀灭试验
乳糖肉汤培养基[含Br麝香草酚蓝];英文名称:Lactose Broth;产品别名:乳糖肉汤培养基基础[含Br麝香草酚蓝];乳糖肉汤培养基[含Br麝香草酚蓝];使用说明:NULL;产品规格:250g/瓶;产品用途:含Br麝香草酚蓝,用于大肠菌群的测定
LB琼脂培养基[Lennox];英文名称:LB Agar,Lennox;产品别名:LB琼脂培养基基础[Lennox];LB琼脂培养基[Lennox];使用说明:称取本品35.0g,加热溶解于1000ml蒸馏水中,分装,121℃高压灭菌15min,备用;产品规格:250g/瓶;产品用途:用于分子生物学中大肠杆菌的培养
淀粉硫酸铵琼脂培养基;英文名称:Starch Ammonium Sulphate Agar(Krassilnikov, 1950);产品别名:淀粉硫酸铵琼脂培养基基础;淀粉硫酸铵琼脂培养基;使用说明:NULL;产品规格:250g/瓶;产品用途:用于链霉菌属的培养鉴定
假单胞菌琼脂培养基F;英文名称:Pseudomonas Agar for Detection of fluorescin;产品别名:假单胞菌琼脂培养基基础F;假单胞菌琼脂培养基F;使用说明:称取本品3.8g于100ml蒸馏水或去离子水中,并加入1支,加热煮沸至完全溶解,分装,121℃高压灭菌15分钟,备用;产品规格:250g/瓶;产品用途:用于假单胞菌荧光素测定,每100ml添加1ml
苛养厌氧菌肉汤培养基;英文名称:Fastidious Anaerobe Broth (FAB);产品别名:苛养厌氧菌肉汤培养基基础;苛养厌氧菌肉汤培养基;使用说明:称取本品29.7g于1L蒸馏水或去离子水中,加热煮沸至完全溶解,分装,121℃高压灭菌15分钟,灭菌结束后迅速冷却,备用;产品规格:250g/瓶;产品用途:用于厌氧菌的增菌培养,含0.075%琼脂
庆大霉素琼脂培养基;英文名称:Gentamicin Agar Base;产品别名:庆大霉素琼脂培养基基础;庆大霉素琼脂培养基;使用说明:称取本品56.0g,加热搅拌溶解于1000ml蒸馏水中,冷至50℃左右时,加入无菌1%亚碲酸钾溶夜0.5ml,混匀,倾入无菌平皿,备用。无需高压灭菌;产品规格:250g/瓶;产品用途:用于霍乱弧菌选择性分离,每100ml添加1支庆大霉素琼脂基础添加剂
MMO-MUG培养基;英文名称:Minimal Medium ONPG-MUG;产品别名:MMO-MUG培养基基础;MMO-MUG培养基;使用说明:称取本品2.7±0.5g于100ml水样中,混匀溶解,36±1℃培养24h,观察结果;产品规格:100g/瓶;产品用途:用于总大肠菌群酶底物法检测
M17肉汤培养基[进口原料];英文名称:M17 Broth;产品别名:M17肉汤培养基基础[进口原料];M17肉汤培养基[进口原料];使用说明:称取本品3.g于95ml蒸馏水或去离子水中,加热煮沸至完全溶解,分装121℃高压灭菌15分钟,冷至50℃,无菌操作加入无菌的10%乳糖溶夜5ml,混匀,备用;产品规格:100g/瓶;产品用途:用于牛奶和乳制品中乳酸菌的检测,每100ml添加1支10%乳糖溶夜
"

![大豆酪蛋白琼脂培养基基础[含卵磷脂]](https://img.chemicalbook.com/SupplyImg/2020-06-02/Large/202006020856437812044.jpg)